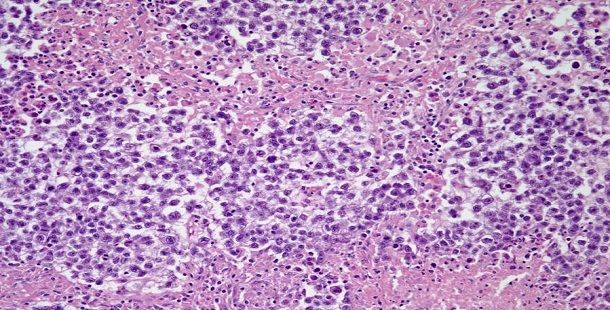

In 2016, it is estimated that there will be 22,280 newly diagnosed cases of ovarian cancer in the United States. Astonishing as it may seem, the lifetime risk for a woman developing ovarian cancer is 1 in 75, with a risk of death related to the disease being 1 in 100 (excluding low malignant potential tumors).